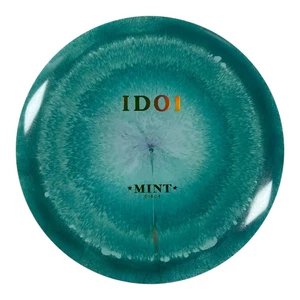

Picture 1 of 1
Gallery
Picture 1 of 1

Have one to sell?
Idol | Elixir | Teal/Green Holo 164g (First Run)
US $19.99
ApproximatelyRM 84.55
Condition:
Please select a Weight
Last one
Oops! Looks like we're having trouble connecting to our server.
Refresh your browser window to try again.
Shipping:
US $5.54 (approx RM 23.43) USPS Ground Advantage®.
Located in: Little Rock, Arkansas, United States
Save on combined shipping
Delivery:
Estimated between Sat, 25 Oct and Wed, 29 Oct to 94104
Returns:
30 days return. Seller pays for return shipping.
Coverage:
Read item description or contact seller for details. See all detailsSee all details on coverage
(Not eligible for eBay purchase protection programmes)
Seller assumes all responsibility for this listing.
eBay item number:326733483183
Item specifics
- Condition
- MPN
- 87385824
- Brand
- Mint Discs
Item description from the seller
Popular categories from this store
Seller feedback (9,102)
- l***r (125)- Feedback left by buyer.Past yearVerified purchasePurchased from multiple times. Everything as expected and promised. Good packaging and fast to ship. Outstanding customer service. They had a small inventory issue allowed me to select 2 of a specific color stamp, when only 1 was available. They reached out the following morning in less than 12 hours apologizing and with multiple options. Outcome got the same disc weight color and same stamp just dif highlight color. Great experience couldn’t be happier. Will keep buying from this shop.Votum | Ethereal | Blue/Gold 169g (#325807828816)
- y***r (421)- Feedback left by buyer.Past monthVerified purchase5 stars isn't nearly enough for Perks and Re-creation. I placed an order for the blue Dynamic Disc Trooper bag. The next day I received a phone call, I didn't know the number but it was from Arkansas. It's was I think his name is Jeremy, he told me they had an inventory issue and didn't have the one I ordered. We worked it out, and I got the bag I was going to originally order. They could've just canceled my order, and yet, they took the time to call. They got a customer for life!!
- r***g (37)- Feedback left by buyer.Past 6 monthsVerified purchaseFast shipping with tracking. Was just as pictured. Cheaper than buying directly from the site, when they’re not sold out. Was packaged carefully and arrived in great condition.Zuca Backpack Cart Trekker LG | Blue Frame with Charcoal Bag (#326547844855)
More to explore :
- Running & Jogging Green Running Belts,
- Green Running Gloves,
- Green Running Belts,
- Innova First Run Discs Disc Golf,
- Running & Jogging Green Running Lights Gear,
- Green GPS & Running Watches,
- Garmin Green GPS & Running Watches,
- adidas Running & Jogging Green Fitness & Running Shoes for Men,
- Nike Running & Jogging Green Fitness & Running Shoes for Men,
- Running & Jogging GPS & Running Watches